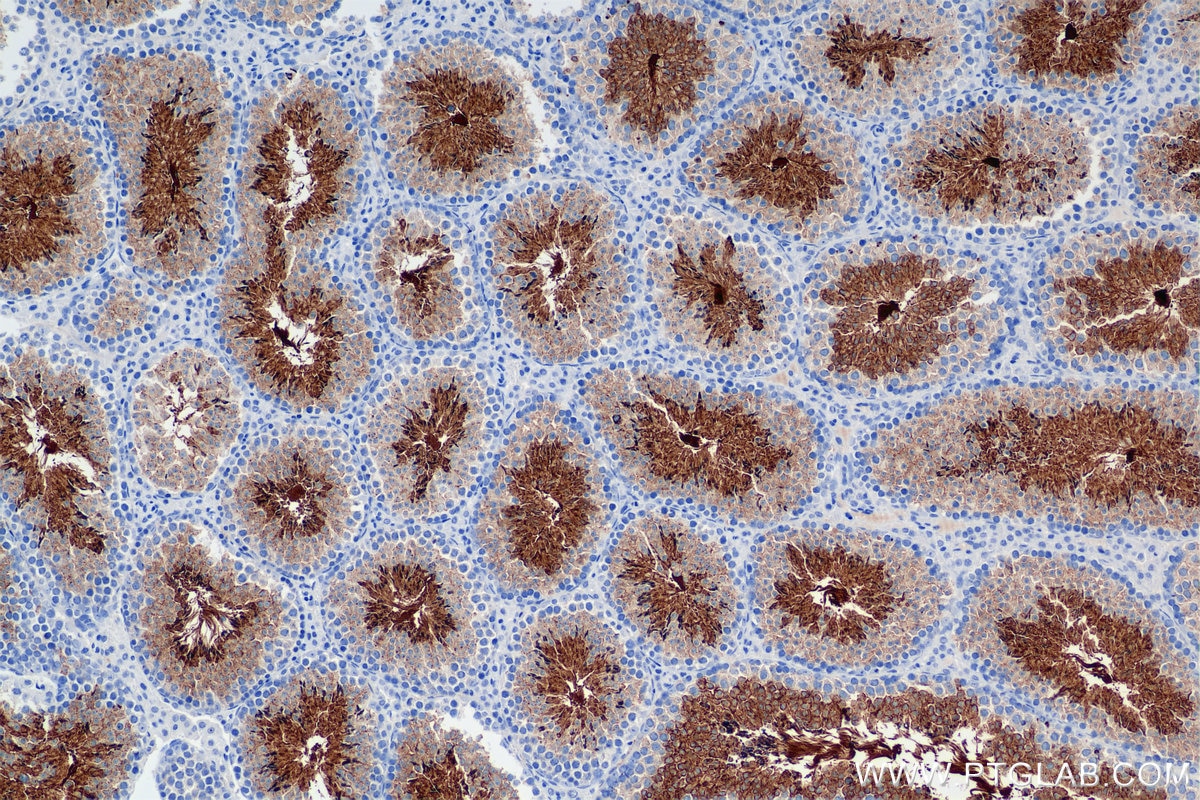
Immunohistochemistry (IHC) staining of mouse testis tissue using CD55 Recombinant antibody (84519-6-RR)
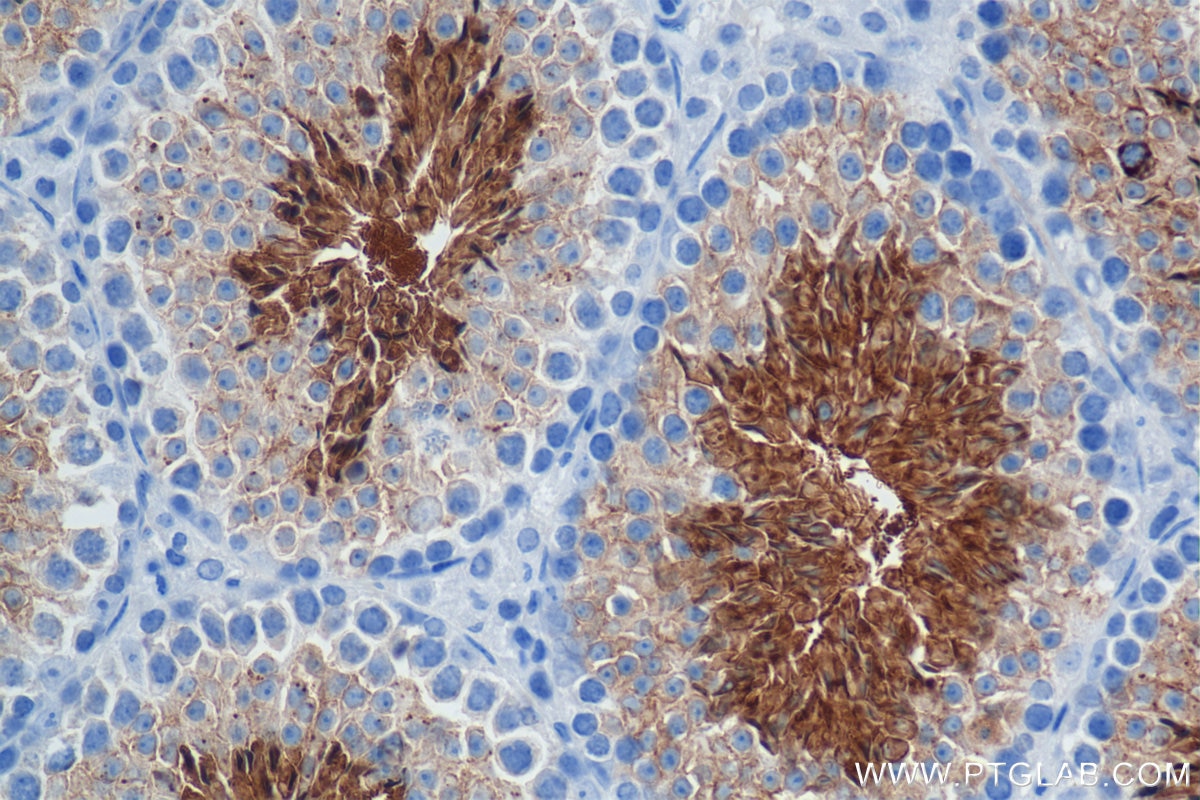
Immunohistochemistry (IHC) staining of mouse testis tissue using CD55 Recombinant antibody (84519-6-RR)

Tested Applications
| Positive WB detected in | mouse testis tissue, mouse spleen tissue |
| Positive IHC detected in | mouse testis tissue, mouse spleen tissue Note: suggested antigen retrieval with TE buffer pH 9.0; (*) Alternatively, antigen retrieval may be performed with citrate buffer pH 6.0 |
Recommended dilution
| Application | Dilution |
|---|---|
| Western Blot (WB) | WB : 1:5000-1:50000 |
| Immunohistochemistry (IHC) | IHC : 1:500-1:2000 |
| It is recommended that this reagent should be titrated in each testing system to obtain optimal results. | |
| Sample-dependent, Check data in validation data gallery. | |
Product Information
84519-6-RR targets CD55 in WB, IHC, ELISA applications and shows reactivity with mouse samples.
| Tested Reactivity | mouse |
| Host / Isotype | Rabbit / IgG |
| Class | Recombinant |
| Type | Antibody |
| Immunogen |
CatNo: Eg2124 Product name: Recombinant Mouse CD55 protein (rFc Tag)(HPLC verified) Source: mammalian cells-derived, pHZ-KIsec-C-rFc Tag: C-rFc Domain: 35-361 aa of NM_010016.3 Sequence: DCGPPPDIPNARPILGRHSKFAEQSKVAYSCNNGFKQVPDKSNIVVCLENGQWSSHETFCEKSCVAPERLSFASLKKEYLNMNFFPVGTIVEYECRPGFRKQPPLPGKATCLEDLVWSPVAQFCKKKSCPNPKDLDNGHINIPTGILFGSEINFSCNPGYRLVGVSSTFCSVTGNTVDWDDEFPVCTEIHCPEPPKINNGIMRGESDSYTYSQVVTYSCDKGFILVGNASIYCTVSKSDVGQWSSPPPRCIEKSKVPTKKPTINVPSTGTPSTPQKPTTESVPNPGDQPTPQKPSTVKVSATQHVPVTKTTVRHPIRTSTDKGEPNT Predict reactive species |
| Full Name | CD55 antigen |
| Calculated Molecular Weight | 43kDa |
| Observed Molecular Weight | 55-65 kDa |
| GenBank Accession Number | NM_010016.3 |
| Gene Symbol | CD55 |
| Gene ID (NCBI) | 13136 |
| Conjugate | Unconjugated |
| Form | Liquid |
| Purification Method | Protein A purification |
| UNIPROT ID | Q61475 |
| Storage Buffer | PBS with 0.02% sodium azide and 50% glycerol, pH 7.3. |
| Storage Conditions | Store at -20°C. Stable for one year after shipment. Aliquoting is unnecessary for -20oC storage. 20ul sizes contain 0.1% BSA. |
Background Information
CD55, also known as DAF, is a glycosylphosphatidylinositol (GPI)-anchored surface glycoprotein that is widely distributed on blood, stroma, epithelial, and endothelial cells (PMID: 7517044; 29503741). It can also exist as a soluble form in plasma, urine, saliva, tears, and synovial fluids (PMID: 29503741). CD55 is a complement regulatory protein (PMID: 2469439; 7517044). It inhibits formation of the C3 convertases through binding to C3b and C4b. It also binds the alternate pathway convertase C3bBb, the classical pathway convertase and C4b2a to accelerate their decay (PMID: 17289551). CD55 also serves as a receptor for coxsackieviruses B1, B3, and B5 and several enteroviruses (PMID: 7538177; 7517044). The observed molecular weight of mature CD55 varies between 50 to 100 kDa depending on the cell type. Different sizes of CD55 might be caused by alternative splicing or different glycosylation patterns (PMID: 29503741).
Protocols
| Product Specific Protocols | |
|---|---|
| IHC protocol for CD55 antibody 84519-6-RR | Download protocol |
| WB protocol for CD55 antibody 84519-6-RR | Download protocol |
| Standard Protocols | |
|---|---|
| Click here to view our Standard Protocols |